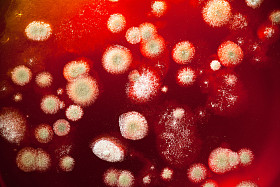

珊瑚殖民地的照片
图片基本信息
图片ID:11391
图片大小:7.80MB
图片尺寸:4288 x 2848 像素
颜色模式:RGB
文件格式:JPG
推荐软件:PS,AI
用途:旅游
构图:横图
版权说明:如需购买商用授权,请购买企业VIP
授权对象:企业,个人
图司机为设计师提供高清珊瑚殖民地的照片图片版权下载,图片为旅游,大小为7.80MB,尺寸为4288 x 2848px,更多关于红色κόκκινο Ζωολογία,颜色,华美,设计,旅行,性质,水机,生活,动物,沧海,照片,热带,景观,元素,鱼,解梦,泡沫,海洋,旅游,在,度假,水族馆,水下,海军陆战队员,水生,跳水运动,樂園,怪鱼,埃及,异国情调,浮潜,潜水,探索,没有,咸水,探險,生物礁,香水,的,珊瑚,以色列,地方,加勒比海,资源管理器,鳌鱼,一家,跳水运动员,殖民地,hardcoral,德,佛罗里达州,泊松,沙,巴哈马,斐济,Mer,礁,群礁,coloridos,海洋动物,造礁珊瑚,peixes,okyanus,coralien商用高清版权图片,快来图司机免费下载吧。